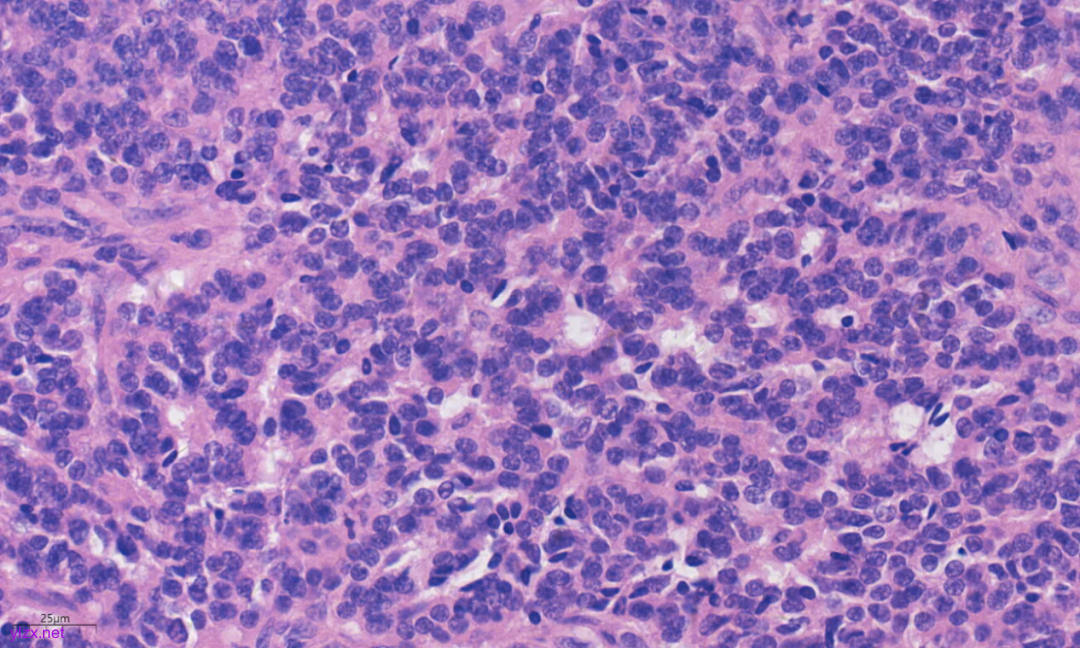
图片

病例分享 | 原发性心脏神经内分泌肿瘤一例
时间:2025-04-04 12:09:10 热度:37.1℃ 作者:网络
01 病史:
女,51岁,因“反复腹泻2年,再发伴腹痛3天”入院。
02 辅查:
心脏B超:左心室见大小约39mm×27mm等回声团。
左心室超声造影:左室后内乳头肌未显示,内后乳头肌处见大小约45mmx28mm均质肿瘤,较心肌造影显像强,与左室后下壁相连基底宽约20mm。
03 组织病理活检:
● 3.1大体肉眼观:
灰黄肿块,体积3×2×1.5cm,切面灰黄,质中,包膜完整。
● 3.2镜下观(图1-图5):
镜下所见,低倍镜下见肿瘤包膜完整、边界清楚,呈器官样结构,即肿瘤细胞排列成实性团巢、条索、缎带状、小梁状、小腺管状或菊形团样。高倍镜下瘤细胞大小比较一致,呈圆形或多角形,胞界不清,大部分胞浆嗜酸,少许胞浆略透亮,染色质细颗粒状,无明显异型性,核分裂象少见。肿瘤细胞巢之间为丰富的血窦和少量纤维间质。

图1 低倍镜下见肿瘤包膜完整、边界清楚。

图2 肿瘤呈器官样结构。

图3 肿瘤细胞排列成实性团巢、条索、缎带状、小梁状、小腺管状或菊形团样。
图4 高倍镜下瘤细胞大小比较一致,呈圆形或多角形,胞界不清,染色质细颗粒状。

图5 肿瘤细胞巢之间为丰富的血窦和少量纤维间质。
● 3.3免疫组化:
肿瘤细胞:CK(+)(图6),CD56(+)(图7),CgA(+)(图8),Syn(+)(图9),MyoD1(膜+),NSE(+),S100(-),Desmin(-),SMA(-),Vimentin(-),Ki-67(2%+)(图10)。

图6 免疫组化示肿瘤细胞CK(+)

图7 免疫组化示肿瘤细胞CD56(+)

图8 免疫组化示肿瘤细胞CgA(+)

图9 免疫组化示肿瘤细胞Syn(+)

图10 免疫组化示肿瘤细胞Ki-67(2%+)
04 病理诊断:
(左心室):神经内分泌肿瘤(NET,G1)。
讨 论
01 背景:
心脏肿瘤罕见,尸检发现原发性心脏肿瘤的发生率为0.001~ 0.030%,良性多于恶性,最常见的为黏液瘤。左心室原发性肿瘤则更为罕见,仅占全部心脏肿瘤的2.5~5%。原发性心脏神经内分泌肿瘤是一种极为罕见的心脏恶性肿瘤,起源于神经内分泌细胞。神经内分泌肿瘤最常发生在胃肠道、肺部和胰腺,极少发生在心脏。神经内分泌肿瘤包含了由高分化到低分化的肿瘤谱系,包括高分化神经内分泌瘤(neuroendocrine tumor ,NET)和低分化神经内分泌癌(neuroendocrine carcinoma ,NEC)。
神经内分泌肿瘤新版WHO采取的3级分级系统适用于大多数NET,特别是胃肠胰,结合核分裂数及Ki67阳性指数将NET分成G1、G2、G3级别。我们认为可以将此分类分级方法应用到心脏神经内分泌肿瘤的诊断上。虽然原发性心脏肿瘤的发生率极低,但它的潜在致死性和可治愈性,使其早期诊断在临床上显得十分重要。
02 临床病理特征 :
● 2.1临床特点
神经内分泌肿瘤的临床症状通常是非特异性的,包括腹痛、腹泻、间歇性肠梗阻和胃肠道出血。心脏肿瘤的临床表现比较复杂、无特异性,肿物突入心腔内,可引起血流动力学障碍。肿瘤局部浸润可损伤心脏传导系统和冠状动脉,引起胸痛、心肌梗死、心律失常、心传导阻滞或猝死。由于心脏神经内分泌瘤临床症状无特异性,且其临床表现常与其他心脏病相似,故容易误诊。
● 2.2影像学特点
影像学特征方面,原发性心脏神经内分泌肿瘤无特殊的影像学表现,仅凭影像学,几乎无法做出准确的诊断。但心脏B超、心脏超声造影、CT及MRI等可以显示占位性病变,使得心脏肿瘤患者得到及时的诊断和治疗。
● 2.3病理学特征
大体观:通常表现为境界清楚的息肉状或实性肿块,质地较软。这些肿瘤富于血管,颜色较暗或可能有灶状出血,固定后呈黄色。
镜下观:肿瘤的组织学形态与其他部位者相同,排列方式多样,可呈岛状、小梁状、腺样、菊形团或弥漫成片,周边有时呈栅栏样排列。瘤细胞大小较一致,呈圆形、多角形,胞质略嗜酸性,胞界不清。核单一、圆形,染色质细颗粒状,核分裂象少见。间质由丰富的薄壁血管和纤细的纤维组织间隔组成,前者是神经内分泌肿瘤的一个显著特征。瘤细胞巢在制片过程中由于收缩而与周围纤维形成空隙结构,易误诊为脉管侵犯。可有神经侵犯。
免疫表型:本例肿瘤细胞:CK(+)证实为上皮来源;CD56(+)、CgA(+)、Syn(+)、NSE(+)证实为神经内分泌来源。其他免疫组化标志物:Vimentin(-)说明不是间叶来源;Desmin(-),SMA(-)除外平滑肌源性肿瘤;S100(-)除外神经源性肿瘤及恶性黑色素瘤;MyoD1膜+而不是核+,除外横纹肌肉瘤。Ki67(2%+)说明肿瘤增值活性很低,根据形态学特征及免疫组化结果,结合临床病史及影像学检查结果提示只有心脏占位,而胃肠道、胰腺、肺及其它部位均未查到病灶,故诊断为(左室)原发性神经内分泌肿瘤(G1)。
分子遗传学:NET常发生MEN1、ATRX和DAXX基因突变。
03 鉴别诊断:
在鉴别诊断方面,原发性心脏神经内分泌肿瘤极为罕见,在病理诊断中需与副神经节瘤、转移性神经内分泌肿瘤、神经内分泌癌、血管球瘤、腺泡状软组织肉瘤、腺泡状横纹肌肉瘤等进行鉴别,病理组织学形态及免疫组化标记可帮助鉴别。
(1)副神经节瘤:虽然与其组织学形态相似,且免疫组化标记物CgA、SyN、CD56等均阳性表达,但副神经节瘤中肿瘤细胞GATA3核阳性表达,支持细胞S100阳性表达。
(2)转移性神经内分泌肿瘤:其他部位有原发神经内分泌肿瘤病史,病灶常为多发,结合临床病史及影像学检查,首先排除其他部位转移再考虑原发。
(3)神经内分泌癌:虽然与其具有相同的免疫组化标记,但神经内分泌癌中肿瘤细胞异型性明显、有坏死且有较多核分裂象,Ki67阳性指数较高。
(4)血管球瘤:细胞形态与其相似,均与血管关系密切,但血管球瘤SMA阳性表达,神经内分泌标记及上皮标记阴性。
(5)腺泡状软组织肉瘤:两者间质均有丰富的薄壁血管,腺泡状软组织肉瘤通常呈实性或腺泡状排列,肿瘤细胞较大,与神经内分泌瘤类似。但免疫组化标记物CD68 阳性,而 CgA、Syn阴性。
(6)腺泡状横纹肌肉瘤:主要由分化较差的小圆形及卵圆形细胞组成,瘤细胞呈不规则的实体状细胞巢及腺泡状结构。腺泡或巢之间由致密的纤维结缔组织隔开。肿瘤内尚可见到不同发育阶段的横纹肌母细胞不规则排列。免疫组化MyoD1、Moyglobin及desmin阳性表达可与其鉴别。
04 治疗及预后:
心脏神经内分泌肿瘤属于低度恶性肿瘤,虽然这类肿瘤通常生长缓慢,但预后取决于疾病的程度。任何心脏肿瘤即使是组织学上被视为良性,都会因其大小和在心脏内的位置不同对血流动力学或心律失常产生巨大影响,给临床医生在诊断和治疗上带来极大的挑战。医生需要综合考虑肿瘤的大小、形态、位置、病理类型以及患者的具体情况,以制定个性化的治疗方案。若未出现严重并发症且符合手术指征,手术切除是目前治疗左心室良性及低度恶性肿瘤的首选方法。由于左心室功能非常重要,绝大多数患者需要尽早手术治疗,减少或避免严重并发症,减少远期复发,使患者获得较长的生存期。
参考文献
[1]Grebenc M L, Rosado de Christenson M L, Burke A P, et al. Primary cardiac and pericardial neoplasms: radiologic-pathologic correlation[J]. Radiographics, 2000, 20(4): 1073-1103.
[2]胡盛寿,王小啟,许建屏,孙立忠,刘迎龙.心脏肿瘤外科治疗经验总结[J].中华医学杂志,2006,86(11):766-770
[3]姚建民,成杞润,贾清仁,任林生,卢宁,赵向东,李文,张笑萌.原发性左心室肿瘤的诊断与治疗[J].中国胸心血管外科临床杂志,1997,4(4):219-220
[4]Bordi C, Yu J Y, Baggi M T, et al. Gastric carcinoids and their precursor lesions. A histologic and immunohistochemical study of 23 cases[J]. Cancer, 1991, 67(3): 663-672.
[5]中国胃肠胰神经内分泌肿瘤病理专家组.中国胃肠胰神经内分泌肿瘤病理学诊断共识[J].中华病理学杂志,2011,40(4):257-262
[6] Majano-Lainez R A .Cardiac Tumors: A Current Clinical and Pathological Perspective[J].Critical Reviews in Oncogenesis, 1997, 8(4):293-303.
[7] Chitwood W R .Cardiac Neoplasms: Current Diagnosis, Pathology, and Therapy[J].Journal of Cardiac Surgery, 2010, 3(2):119-154.
[8]Mathur A, Airan B, Bhan A, et al. Non-myxomatous cardiac tumours: twenty-year experience[J]. Indian heart journal, 2000, 52(3): 319-323.
[9] Quaedvlieg P F H J, Visser O, Lamers C B H W, et al. Epidemiology and survival in patients with carcinoid disease in the Netherlands: an epidemiological study with 2391 patients[J]. Annals of oncology, 2001, 12(9): 1295-1300.

